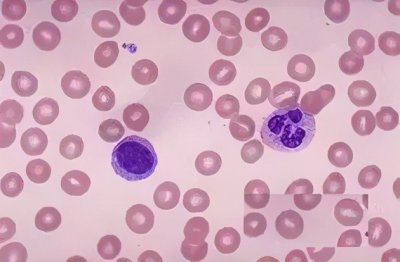
​NKT细胞——人体的守护天使

俞凌雄,一位网红企业家
俞凌雄,一位网红企业家

今天无意之中看了俞凌雄先生的一段演讲视频,短短20多分钟的视频却深深的吸引我,故特聊聊俞凌雄先生。
俞凌雄,投资家、企业家、创业家导师。上海浙商实业集团有限公司董事长、浙创资本投资有限公司董事长、上海汇聚投资有限公司董事长、上海凌雄大爱公益基金会理事长、中国社会福利基金会荣誉理事。俞凌雄于2007年创立汇聚领航,现已成为国内最大的企业家学习平台,行业领军企业,并积极缔造中国新商业生态体系和持续推动新商业文明的进化。2014年将旗下公司整合,组建上海浙商实业集团,打造全球领先的战略投资集团,公司投资、构筑、驱动、重塑,包括金融、互联网+、教育、农业、环保、健康等广泛领域。
然而在此之前,他没有背景,没有学历,亲戚看不起他,甚至不让他在一张饭桌上吃饭。很早就辍学打工,经历过没有饭吃,天天饿肚子,晚上只能睡公园的窘境,甚至还遇到了人生中第一个“同性恋”,生活在社会的最底层。但他没有放弃,立志改变家族命运的梦想一直支撑着他。如今他站得更高,走得更远。
2016年,,一则视频火遍网络:10天, 7000万点击量,每20个中国人中就有一个看过,百度搜索指数超过马云+任正非之和,且势头不减,其中的正能量、希望、梦想等,引发全民关注、讨论、转发。
这是一则什么样的视频?
这是一段25分钟的走心演讲,一段震撼人心的人生经历分享,期间的每一次停顿和留白,都会燃起经久不息的热烈掌声。不少现场听众流下热泪、心潮澎湃。他用真实、真诚、真切的人生经历传递正能量,勾起人们心中柔软的共鸣,也唤醒所有人内心顽强的斗志。
视频中他说,“所有苦难,都是我俞凌雄人生成长的肥料”;“要永远保持你们的梦想!不管有多少人反对都不要改变你们的梦想,让梦想成为你灵魂的支柱,永远都不动摇,只要不动摇,总有一天你会成为你自己生命的主人,任何人都无法撼动。”
1、7岁立志做大事,长大后要在央视春晚恭贺全国人民“新年快乐”。
2、经常替同学两肋插刀,在同学心中威信非常高,一直是孩子们的领袖。
3、从小独立,凡事自己拿主意,培养了强大自我,独立精神。
4、天生自信,不盲目崇拜,骨子里认为别人能做到的自己也能做到,别人不能做到的,他照样能做到。
5、从小有经济头脑 小学开始做生意赚钱,一直是孩子里面最富有的人。
步入社会/
1、刚入社会,人生迷茫。为了生存做过保安、仓库保管员、厨师、服务员,不知理想如何实现。偶然机会受一老板指点:要做大老板,最好做业务员。当天晚上就和五个同事约好一起辞职,结果第二天就他一人辞职。
2、事业启蒙期。向大师学习并从事业务工作,第一个月就做到公司第一名;同时经客户介绍,开始接触教育培训行业,从此变成学习专业户,至今为止投了800多万学习费用。
3、高速成长期。从19岁做业务员开始,历任经理、大区主管、销售部经理; 23岁做中国百强企业营销副总;24岁成为上市公司营销副总;25岁管理一家三千人规模的大集团,任总裁;2007年12月1日,选择创业,创办汇聚投资。
壮大腾飞/
2011年,构建的企业家教育生态圈优势尽显,进一步夯实行业领军企业的地位。
2012年带领公司进入多元化,开始进军金融、互联网等领域,布局企业家生态圈、互联网生态圈和公益生态圈,荣获“十大魅力浙商”大奖。
2013年成立第一资本,进入资产重组,股权投资,企业上市等业务板块,正式发力金融领域。
2014年将旗下公司整合,组建上海浙商实业集团,打造全球领先的战略投资集团。
2015年制定 “三线一圈”战略:通过金融大生态、互联网+、企业家全维进化三大战略创建多元生态圈的全球化经济体。其首创的多元生态圈模式因此荣获“中国最佳商业模式奖”。2015年,将金融大生态战略定位为集团未来核心战略,致力打造万亿级新商业生态系统,成立浙融投资、盈衡资产,惠昌基金等公司,浙商实业金融生态圈战略全面起航。
2016年,浙创资本成立,“三线一圈”战略再次升级,三大战略互动互生互长,高度渗透、深层连接,全面构建面向未来的新商业生态体系。
2017年,以十年积累核心优势更上层楼,创办道商学院,将是中国第一个以宇宙智慧贯通新商业系统的商学院,力争与诸多合作伙伴,一年成为行业标杆,缔造出符合中国商业环境的新一代商学院!
-

- 拿破仑称帝:从小个子到大帝国的逆袭传奇
-
2025-07-17 07:26:28
-
- 李实是个什么人?
-
2025-07-17 07:24:13
-

- 50年前风靡的伊拉克蜜枣,因谣言销声匿迹?实则已“改头换面”
-
2025-07-17 07:21:58
-
- NKT细胞——人体的守护天使
-
2025-07-17 07:19:42
-

- 全国最好的医院排行榜(综合实力排名)
-
2025-07-17 07:17:27
-

- 买华为P30Pro还是选Mate20Pro?店老板的回答一针见血,很中听
-
2025-07-17 07:15:12
-

- 提前预知《大主宰》结局 牧尘的女儿又有何种传奇
-
2025-07-16 04:20:15
-

- 什么是抽象艺术?认识一下吧!
-
2025-07-16 04:18:00
-

- 上饶“青蓝国际”地产烂尾数年,目前出台的解决方案是……
-
2025-07-16 04:15:45
-

- 教你如何玩转腕力球
-
2025-07-16 04:13:30
-

- 翡翠雕刻题材很多,今天介绍的是,阿氏多尊者——长眉罗汉
-
2025-07-16 04:11:15
-

- 《西游记》狮驼岭之大鹏金翅雕
-
2025-07-16 04:09:00
-

- 伊朗最高领袖哈梅内伊
-
2025-07-16 04:06:45
-

- 信球,圣人蛋
-
2025-07-16 04:04:30
-

- 先导溢流阀工作原理,看了就能懂
-
2025-07-16 04:02:15
-

- 如何看待“师生恋“现象?
-
2025-07-16 04:00:00
-
- 个人所得税-系列-取得的稿酬如何计算缴纳个人所得税呢?
-
2025-07-16 03:57:45
-

- #(经济)浙江温州:轨道交通S2线开通运营
-
2025-07-16 03:55:30
-

- 湘江战役简史
-
2025-07-16 03:53:15
-

- 计算机的发展趋势
-
2025-07-16 03:51:00



 褚时健当年得罪了谁(褚时健是被谁害的话)
褚时健当年得罪了谁(褚时健是被谁害的话) 钱雁秋最新力作《神探狄仁杰6》卷土重来,张子健回归变反派
钱雁秋最新力作《神探狄仁杰6》卷土重来,张子健回归变反派 十位欧美健身男模,颜值和身材兼备,肌肉帅气十足
十位欧美健身男模,颜值和身材兼备,肌肉帅气十足 法官职务等级及工资揭秘,宝藏级信息
法官职务等级及工资揭秘,宝藏级信息 邱行湘老婆张玉珍生平 邱行湘将军之子邱晓辉
邱行湘老婆张玉珍生平 邱行湘将军之子邱晓辉 卓伟爆料圈内最干净的三位女星,颜值在线还零绯闻,没人质疑
卓伟爆料圈内最干净的三位女星,颜值在线还零绯闻,没人质疑 非你莫属晕倒哥后续(非你莫属晕倒小伙)
非你莫属晕倒哥后续(非你莫属晕倒小伙) 中国最发达省份排名:江苏、福建、浙江居前
中国最发达省份排名:江苏、福建、浙江居前 33年前,英雄徐良凭《血染的风采》家喻户晓,他现在怎样了
33年前,英雄徐良凭《血染的风采》家喻户晓,他现在怎样了 演员甘露个人资料(演员甘露个人资料及照片老公)
演员甘露个人资料(演员甘露个人资料及照片老公)